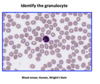

Histology of Blood Cells and Hematopoiesis [LAB] | B2 WK4 Flashcards
Distinguish the histological organization of a red bone marrow core biopsy, bone marrow smear, and peripheral blood smear. Describe and identify erythrocytes, megakaryocytes, and platelets in light and electron micrographs. Recognize and describe the structure of neutrophils, eosinophils, basophils, and monocytes in light and electron micrographs. Describe and identify the structure of lymphocytes in light and electron micrographs.
1
Q

A
A: Neutrophil
B: Lymphocyte
C: RBC (erythrocyte)
2
Q

A
A: Neutrophil
B: RBC
C: Platelet
D: Lymphocyte
3
Q

A
A-C: Neutrophils
4
Q

A
Monocyte
5
Q

A
Monocyte
6
Q

A
Eosinophil
7
Q
A
Basophil
8
Q

A
A: Eosinophil
B: Neutrophil
9
Q

A
Eosinophil
10
Q

A
A: Neutrophil
B: Band Cell
11
Q

A
A: Adipose
B: Bone (trabeculae)
C: Hemopoietic Cord
12
Q

A
Megakaryoblasts
(cells that give rise to platelets)
13
Q

A
A: Hemopoietic Cord
B: Adipocyte
C: Arteriole
D: Sinusoid
E: Magakaryocyte
14
Q

A
bone marrow sinusoids
[between adipose – long trails]
15
Q

A
A: Sinusoids
B: Stromal Cells
C: Bone
D: Hematopoietic Cord
16
Q

A
A: Adipose
B: Megakaryocytes
C: Hemopoietic cells
17
Q

A
Normoblast
18
Q

A
A: Band Cells